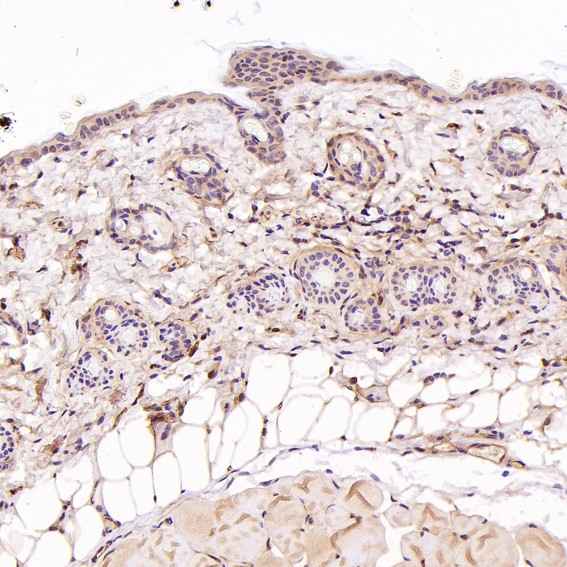
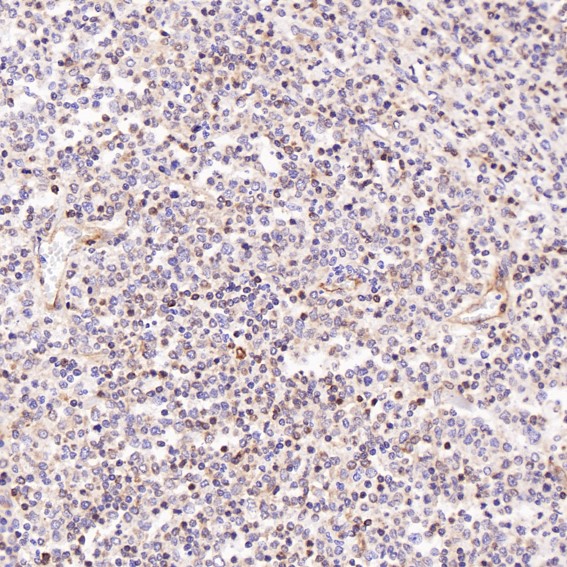

单克隆抗体
Phospho-SIRT1 (S47) Antibody (CY5668)
UniProt:Q96EB6
Application:WB,IHC,ICC/IF
Reactivity:Human
Source:Rabbit mAb
Phospho-SIRT1 (S47) Antibody (CY5668)
UniProt:Q96EB6
Application:WB,IHC,ICC/IF
Reactivity:Human
Source:Rabbit mAb
http://www.abways.cn/showproduct.asp?cid=CY5668
P Glycoprotein Antibody (CY5669)
References (1)
UniProt:P08183
Application:WB,IHC
Reactivity:Human,Mouse,Rat
Source:Rabbit mAb
P Glycoprotein Antibody (CY5669)
UniProt:P08183
Application:WB,IHC
Reactivity:Human,Mouse,Rat
Source:Rabbit mAb
References(1)
http://www.abways.cn/showproduct.asp?cid=CY5669
Troponin T Antibody (CY5670)
UniProt:P45379
Application:WB,IHC
Reactivity:Human,Mouse,Rat
Source:Rabbit mAb
Troponin T Antibody (CY5670)
UniProt:P45379
Application:WB,IHC
Reactivity:Human,Mouse,Rat
Source:Rabbit mAb
http://www.abways.cn/showproduct.asp?cid=CY5670
FNTB Antibody (CY5671)
UniProt:P49356
Application:WB,ICC/IF
Reactivity:Human,Rat
Source:Rabbit mAb
http://www.abways.cn/showproduct.asp?cid=CY5671
Phospho-CrkII (Tyr221) Antibody (CY5672)
UniProt:P46108
Application:WB,ICC/IF
Reactivity:Human
Source:Rabbit mAb
Phospho-CrkII (Tyr221) Antibody (CY5672)
UniProt:P46108
Application:WB,ICC/IF
Reactivity:Human
Source:Rabbit mAb
http://www.abways.cn/showproduct.asp?cid=CY5672

销售咨询
一键电话